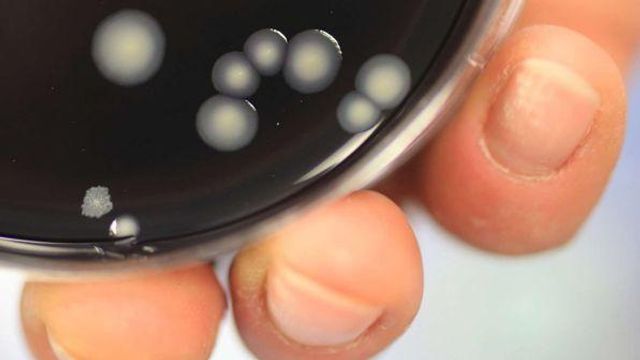

I carabinieri del Nas di Trento hanno denunciato per omicidio colposo 8 titolari di strutture ricettive dell'Altopiano della Paganella, accusati di essere stati responsabili della morte di tre turisti. Secondo le indagini dei militari, gli albergatori non avevano predisposto il piano di valutazione del rischio legionellosi (obbligatorio dal 2015), e a causa di ciò 19 turisti si sono ammalati di legionella nell'estate 2018, e 3 di loro sono morti.
Grave sottovalutazione del rischio - Gli accertamenti dei Nas hanno insomma messo in luce una grave sottovalutazione del rischio legionellosi nelle strutture interessate, facendo emergere una serie di anomalie: dalla mancanza di un'adeguata manutenzione degli impianti termo-sanitari alla non corretta gestione delle temperature nella rete di distribuzione interna, fino ai serbatoi di accumulo dell'acqua calda sanitaria, di molto inferiore a quanto raccomandata dalle relative Linee guida.
Rete idrica contaminata nelle strutture esaminate - I prelievi eseguiti nell'estate del 2018 hanno di conseguenza evidenziato la contaminazione della rete idrica del batterio in quasi tutte le strutture esaminate, in alcuni casi in misura particolarmente elevata. Non c'è stata invece evidenza di contaminazioni della rete idrica comunale.
In particolare, in una delle strutture dove ha soggiornato un turista poi morto, è stato constatato il malfunzionamento di una valvola dell'impianto dell'acqua calda, circostanza che ha favorito il proliferare del batterio. La stessa struttura è stata interessata da quattro casi di notifica di legionella, tra cui uno con il decesso della vittima. Nella stessa stanza hanno soggiornato, in tempi diversi, due dei turisti contagiati. Le persone che si sono ammalate erano in prevalenza anziane. A collaborare alle indagini è stato anche il personale dell'Azienda provinciale per i servizi sanitari di Trento.